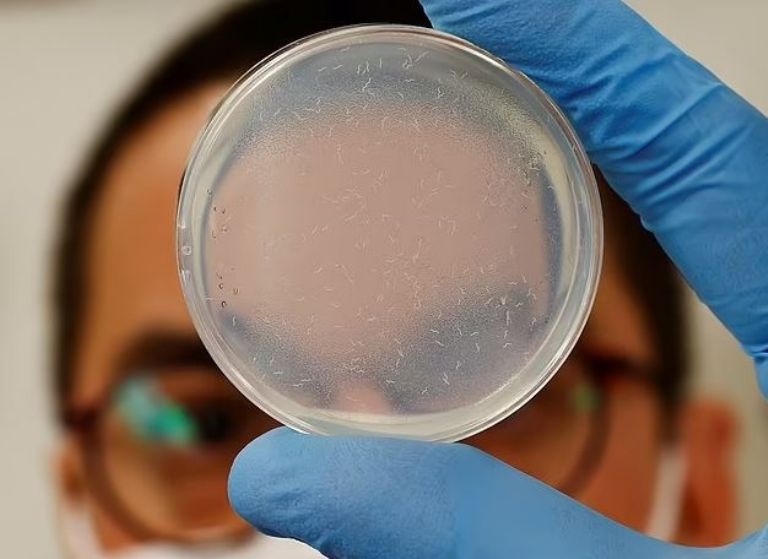
Nematdos

Tokio, Japón.- De acuerdo con información de los Centros para el Control y Detección de Enfermedades Contagiosas (CDC, por sus siglas en inglés) de Estados Unidos, el cáncer de páncreas es una de las enfermedades degenerativas más mortíferas, debido a que no muestra los primeros síntomas a no ser que la afección ya se encuentre muy avanzada; sin embargo, un equipo de científicos de Japón encontró un manera poco convencional de detectar tumores relacionados con esta condición; aseguran que es 100 por ciento efectiva.
El descubrimiento fue realizado recientemente por la empresa de biotecnología Hirotsu Bio Science, cuya sede se encuentra en Tokio, Japón. De acuerdo con algunos informes, el potencial paciente tiene que enviar una muestra de orina a un laboratorio por correo. La evacuación será colocada en una placa Petri, donde será expuesta a varias decenas de gusanos conocidos como nematodos, mismos que miden apenas un milímetro de largo.
Estos curiosos animales, se caracterizan por poseer un alto sentido del olfato; sin embargo, el director ejecutivo y fundador de la compañía, Takaaki Hortsu, altero genéticamente a estos seres para alejarse de cualquier muestra que contenga residuos de cáncer de páncreas. De acuerdo con algunos datos, el equipo de científicos aseguró que esta técnica es altamente efectiva e incluso supero a otros métodos de detección.
Créditos: Reuters
Hirotsu declaró que estas pruebas serían vendidas directamente a los pacientes, por lo que no requeriría la aprobación de organizaciones como la Administración de Alimentos y Medicamentos de Estaos Unidos (FDA, por sus siglas en inglés), por lo que se estima que los pacientes del país gobernado por Joe Biden puedan disponer para el próximo año de esta curiosa prueba de detección.
El experto japonés declaró que es de suma importancia que las personas puedan detectar a esta enfermedad en etapa temprana; "Lo que es muy importante con la detección temprana del cáncer y este tipo de enfermedades es poder detectar cantidades mínimas y cuando se trata de eso, creo que las máquinas no tienen ninguna posibilidad a las capacidades que tienen los organismos vivos".
Fuentes: Tribuna









